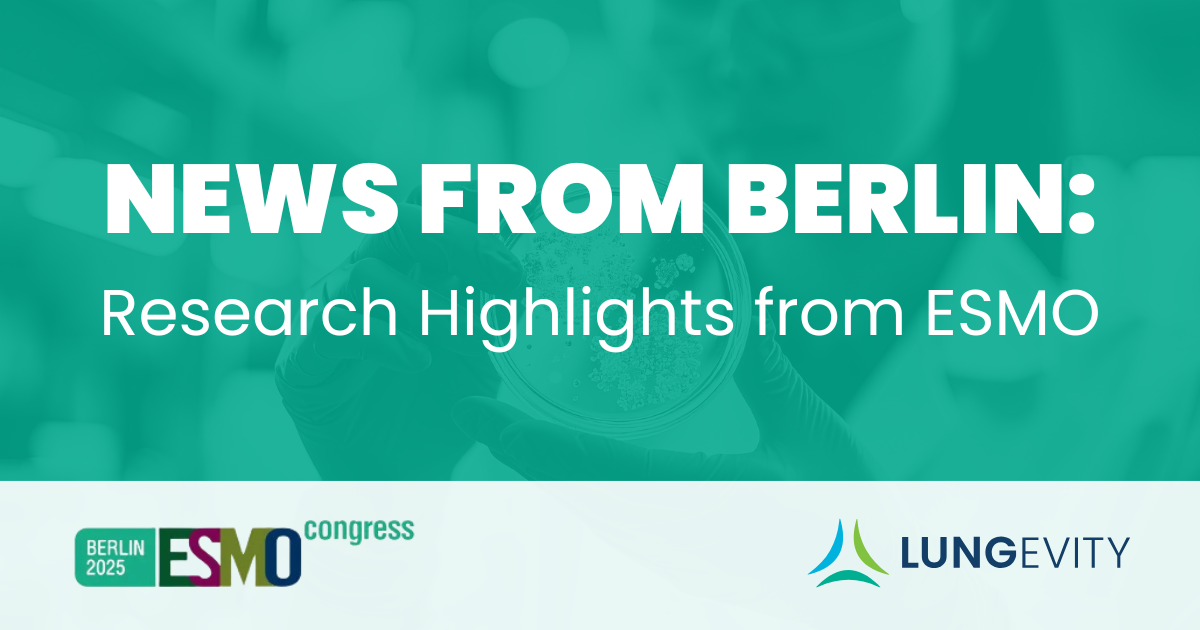

Lung cancer research was in the spotlight at the European Society for Medical Oncology (ESMO) meeting held October 17-21, 2025, in Berlin, Germany. With approximately 30,000 attendees from over 100 countries, this meeting gathered an international audience of clinicians, researchers, patient advocates, and representatives from the healthcare industry to discuss cutting-edge cancer research and share practice-changing clinical trial data.
We saw data from studies that aim to build upon existing treatments, to optimize combination approaches, and to address some of the unmet needs of people living with lung cancer. Below, we highlight impactful lung cancer research presented at #ESMO25.
Progress in Treating Early-stage ALK+ NSCLC
Those with ALK-positive metastatic non-small cell lung cancer (NSCLC) have benefited greatly from the development of tyrosine kinase inhibitors (TKIs). Researchers are now working to bring those benefits to people with earlier stages of disease.
Results from the phase 3 ELEVATE trial demonstrated that treating patients after surgery with chemotherapy followed by ensartinib, a next-generation ALK TKI, resulted in an 80% reduction in the risk of disease recurrence compared to patients who didn’t receive ensartinib. The treatment also reduced cancer recurrence in the central nervous system.
Similarly, data from the phase 3 ALINA trial showed that 94% of patients treated with adjuvant alectinib, another TKI, had a minimum of two years without disease progression, compared to 63% of patients treated with adjuvant chemotherapy.
Taken together, these studies bring hope and excitement for people diagnosed with early-stage ALK-positive NSCLC.
Building on the Benefits from EGFR TKIs
The addition of local consolidated therapy to standard TKI regimen has shown promise in treating advanced EGFR-positive lung cancer. Local consolidated therapy can include radiation, surgery, or a combination approach, to treat primary tumors and sites of metastases to improve patient outcomes. Data from the NorthStar phase 2 clinical trial suggested that treating patients with localized consolidated therapy in addition to osimertinib controlled the cancer for an average of 25.3 months, compared to 17.5 months with osimertinib alone. While additional studies are needed, this is a promising finding that could lead to significant benefits for patients.
Studies are also underway to optimize treatment after tumors become drug-resistant and begin to grow again. The phase 3 OptiTROP-LUNG04 clinical trial compared chemotherapy to an antibody-drug conjugate (ADC) called sacituzumab tirumotecan (or Sac-TMT) in patients with EGFR-positive NSCLC whose cancers had begun to grow during treatment with an EGFR-targeted TKI.
The ADC treatment performed well, holding cancer at bay for an average of 8.3 months, compared to 4.3 months for patients treated with chemotherapy alone. This study offers a promising avenue for treating patients after their cancers progress on TKIs.
The continued momentum for improving treatments for EGFR-positive NSCLC brings hope to patients around the globe.
HER2+ NSCLC: Options for Oral TKIs are Emerging
In August, zongertinib, a HER2-directed TKI, was granted accelerated approval by the FDA for treating patients with unresectable or metastatic HER2-positive NSCLC who have received prior systemic therapy. Researchers at #ESMO25 presented data from the phase 1 Beamion Lung-1 clinical trial that tested zongertinib as a first-line treatment for patients. The results showed that 77% of patients benefited from the treatment and are now being confirmed in the phase 3 Beamion LUNG-2 study.
In the phase 1/2 SOHO-01 clinical trial, researchers studied sevabertinib (another HER2-directed TKI) to treat patients with locally-advanced or metastatic HER2-positive NSCLC. The data showed that more than 70% of patients without prior systemic therapy had their tumors shrink or disappear. Though additional studies are needed, these findings contributed to the FDA’s accelerated approval for the drug in November.
With these two TKIs showing strong benefits for patients, there is a lot of optimism in continuing this momentum and building new approaches for treating people diagnosed with HER2-positive NSCLC.
Deeper Understanding of Emerging SCLC Treatments
Tarlatamab is an exciting bi-specific T-cell engager (BiTE®) that acts like a cellular matchmaker, binding immune T-cells on one side and cancer cells (via a protein called DLL3) on the other. This forces the cells together so the T-cells can destroy the cancer.
In November 2025, the FDA granted full approval to use tarlatamab to treat patients whose cancer progressed during or after chemotherapy, based on a phase 3 clinical trial. Data showed tarlatamab improved overall survival by more than five months compared to chemotherapy.
Through ongoing data analysis, we continue to learn more about this treatment. Data presented at #ESMO25 showed that patients treated with tarlatamab had fewer (and more mild) side effects and infections compared to patients treated with chemotherapy.
There are concerns about a major side effect (cytokine release syndrome) when treating patients with tarlatamab. Cytokine release syndrome occurs when the immune system shifts into overdrive and floods the bloodstream with cytokines, signaling proteins that help regulate inflammation in the body. This boost in cytokines can cause widespread inflammation with the potential to damage organs. To ensure safety, patients receiving tarlatamab are closely monitored.
Deeper analysis presented at the meeting revealed that cytokine release syndrome was mostly mild and occurred in the earliest hours after tarlatamab treatment. During the clinical trial, patients were initially required to stay in the hospital for 48 hours to monitor for cytokine release syndrome, but that requirement was reduced to six hours during the trial.
Researchers are also studying new ways to treat brain metastasis in SCLC. Ideate-Lung01, a phase 3 clinical trial, studied the benefits of using infinatamab deruxtecan (I-DXd) to treat patients with relapsed SCLC and brain metastasis. I-DXd is an ADC that works by binding to a protein called B7-H3 that is commonly found on SCLC cells. This allows I-DXd to deliver a linked drug directly to the tumor cells and avoid damaging healthy tissue, which is particularly important when treating brain metastasis. Encouraging data from the clinical trial showed that 46.2% of patients had brain metastasis shrink with this treatment.
Other promising research studies are underway to develop new approaches for treating SCLC.
Potential New Treatment for Squamous NSCLC
Developing new, effective treatments for squamous NSCLC has been challenging, but researchers are starting to make progress.
HARMONi-6, a phase 3 trial, demonstrated exciting results when testing a combination of ivonescimab plus chemotherapy for patients with advanced squamous NSCLC. Ivonescimab is a bispecific antibody that targets the VEGF and the PD-1 pathways that tumors use to evade the immune system and continue to grow. This treatment was compared to tislelizumab (an anti-PD-L1 monoclonal antibody) plus chemotherapy as a first-line treatment for patients with metastatic squamous NSCLC, regardless of PD-L1 status.
The data showed that treating patients with ivonescimab plus chemotherapy, controlled tumor growth for an average of 11.4 months, compared to 6.9 months for patients treated with the tislelizumab-chemotherapy combination. While additional studies are needed, these results represent the progress on the horizon for patients living with squamous NSCLC.
The results of these clinical trials that were presented at the annual ESMO meeting highlight the momentum in lung cancer research. This work, built on decades of scientific discovery, is poised to bring tremendous breakthroughs to patients across the lung cancer community. If you're interested in more research news, make sure to sign up for our quarterly Research Newsletter.